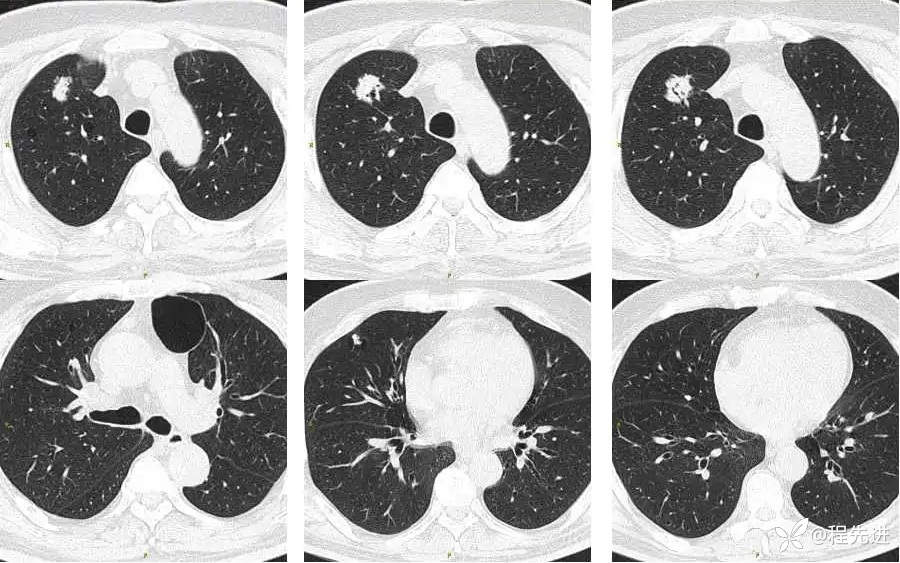
img

【心胸】特别精彩病例|体检发现右肺占3月余
胡志勇HZY 等 4 位达人已点赞病例信息
患者性别:男
患者年龄:67岁
主诉:体检发现右肺占3月余
现病史:患者3月前因干燥综合征在内科治疗时行胸部CT检查发现右肺占位,无特殊不适。病程中患者无畏寒发热、无心悸胸闷呼吸困难、无胸背部胀痛、无声嘶呛咳、无体重减轻,食欲良好,睡眠可,二便无特殊。
既往史:有高血压、糖尿病、干燥综合症病史
CT平扫:



上排与上面同时间,下排是3月后复查

期待您的点赞支持!
期待您的精彩解读!
胡志勇HZY 等 4 位达人已点赞病例信息
患者性别:男
患者年龄:67岁
主诉:体检发现右肺占3月余
现病史:患者3月前因干燥综合征在内科治疗时行胸部CT检查发现右肺占位,无特殊不适。病程中患者无畏寒发热、无心悸胸闷呼吸困难、无胸背部胀痛、无声嘶呛咳、无体重减轻,食欲良好,睡眠可,二便无特殊。
既往史:有高血压、糖尿病、干燥综合症病史
CT平扫:

上排与上面同时间,下排是3月后复查

期待您的点赞支持!
期待您的精彩解读!
